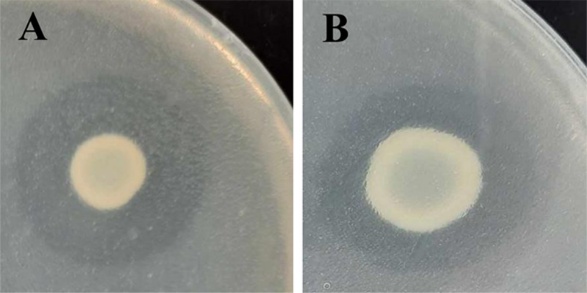

Trends
Sci.
2025; 22(12): 10584
Sequence Analysis and In Silico Characterization of Lipase from Acinetobacter gerneri CE4.3 and PKY2.2
Nicha Charoensri1, Ornampai Japa2, Supakanya Lasom3,
Noppadon Muangsue3 and Piyawan Amimanan3,*
1Centre for Research and Development of Medical Diagnostic Laboratories, Department of Microbiology,
Faculty of Associated Medical Sciences, Khon Kaen University, Khon Kaen 40002, Thailand
2Division of Microbiology and Parasitology, School of Medical Sciences, University of Phayao, Phayao 56000, Thailand
3Department of Medical Technology, School of Allied Health Sciences, University of Phayao, Phayao 56000, Thailand
(*Corresponding author’s e-mail: [email protected])
Received: 8 May 2025, Revised: 18 June 2025, Accepted: 28 June 2025, Published: 20 August 2025
Abstract
Lipase is an enzyme that catalyzes the breakdown of fats into fatty acids and glycerol. Lipase plays a crucial role in various industries. Bacterial lipases are widely studied and utilized in the biotechnology industry because of their adaptability, efficiency in large-scale production, and abundance in lipid-rich environments. The objectives of this research were to isolate and identify lipase-producing bacteria from grease traps in canteens at the University of Phayao. The bacterial isolates were analyzed for the lipase gene through PCR amplification and sequencing. Characteristics of the lipase protein were predicted through in silico studies. The results revealed that the two isolates were Acinetobacter gerneri (A. gerneri) CE4.3 and PKY2.2, which contain the lipase lip50 and lip66 genes. The nucleotide sequences of the lipase genes and amino acid sequences in both strains showed high similarity to the A. gerneri DSM 14967 (EPR83194.1). The predicted physicochemical properties of Lip50 and Lip66 proteins from both strains indicate that they are slightly basic, thermostable, and hydrophilic. Lip50 and Lip66 proteins of both strains contain conserved domains of the lipase enzyme. The analysis of the phylogenetic tree and multiple sequence alignment of Lip50 and Lip66 proteins from both strains indicated that they belong to lipase family V. In conclusion, Lip50 and Lip66 from A. gerneri CE4.3 and PKY2.2 are the foundations for the study of lipase enzymes for biotechnology.
Keywords: Lipase, Lipase genes, Grease traps, Acinetobacter gerneri, In silico, Biotechnology
Lipase (triacylglycerol acylhydrolase, E.C. 3.1.1.3) is an enzyme that plays a significant role in biotechnology and can be widely applied in industries such as the food industry, detergent production, and environmental management [1,2]. Lipases are hydrolases that catalyze the hydrolysis of ester bonds in long-chain triglycerides at the water-oil interface, generating free fatty acids, glycerol, monoglycerides, and diglycerides [3]. Lipases are found in nature and are produced by plants, animals, fungi, and bacteria [4].
At present, bacterial lipases are one of the preferred choices for various applications due to their
ability to produce diverse types of lipases and their stability in organic solvents [5]. Additionally, bacterial lipases are inducible enzymes that are produced in the presence of lipid sources such as oils, triacylglycerols, and fatty acids. This characteristic enables the large-scale production of bacterial lipases [6]. Bacterial lipases are found in various genera such as Acinetobacter, Bacillus, Burkholderia, and Pseudomonas [7-10], which are recognized as important sources of enzymes that play important roles in industrial applications and environmental lipid degradation. These bacteria are commonly isolated from lipid-rich environments such as oily wastewater treatment ponds, fat-rich industrial wastewater, restaurant wastewater, and grease traps, which serve as excellent sources of lipases. Since lipid composition varies across different environments, lipase-producing bacteria from these areas may represent valuable sources of highly efficient lipases for lipid degradation.
A grease trap is a chamber specifically designed to separate fats and oils from wastewater before it is discharged into a treatment system [11]. Grease traps are commonly installed in restaurants or cafeterias. The wastewater accumulated in grease traps contains high levels of organic compounds and lipids [11]. This wastewater serves as a suitable source for isolating lipase-producing bacteria, which play a key role in lipid degradation and have diverse potential applications in biotechnology. However, studies on the isolation of lipase-producing bacteria from grease trap wastewater remain limited compared to those from other sources.
The objective of this study was to isolate lipase-producing bacteria from grease traps of canteens located at the University of Phayao in northern Thailand. In this study, bacterial strains exhibiting lipase production were described following a screening process. These strains were identified as A. gerneri CE4.3 and PKY2.2. To investigate the predicted lipase genes and their enzymatic properties, lipase gene sequences from A. gerneri DSM 14967 were used to design primers for gene detection and nucleotide sequence analysis. Additionally, the properties and structures of the lipase proteins were predicted through in silico analysis. Furthermore, phylogenetic and multiple sequence analyses of their lipase proteins were performed to confirm the high potential of lipase enzymes in A. gerneri CE4.3 and PKY2.2.
Materials and methods
Sample collection and enrichment of lipase-producing bacteria
The wastewater samples were collected from the grease traps of three canteens located at the University of Phayao in northern Thailand, including Phu Kam Yao (PKY) canteen (latitude 19°02'65.9"N; longitude, 99°89'34.3"E), the Classroom Education (CE) Building canteen (latitude 19°03'09.8"N; longitude, 99°89'55.7"E) and Wiang Phayao (WP) canteen (latitude 19°03'23.9"N; longitude, 99°89'09.3"E). Approximately 10 mL of wastewater was collected in sterile plastic bags and transported to the laboratory. The sample was added to 90 mL screening medium (5 g (NH4)2SO4, 5 g Bacto peptone, 1 g MgSO4.7H2O, 5 g KH2PO4, 1 g yeast extract, 0.064 g bromocresol purple, 1,000 mL distilled water) [12] and incubated at 37 °C in a shaking incubator (200 rpm) for 2 days. Subsequently, 1 mL of the enriched lipase-producing bacteria was serially diluted ten-fold in sterile distilled water. Then, 100 µL of each dilution was spread on screening medium agar supplemented with 0.01% olive oil and incubated at 37 °C for 24 h. The yellow colonies were selected for further studies.
Screening of lipase-producing bacterial isolates
Twenty microliters of 108 CFU/mL bacterial isolates in Tryptic Soy Broth (TSB) were inoculated onto a Tributyrin Agar (TA) plate (10 mL of 3.42 M Tributyrin, 5 g peptone, 5 g yeast extract, 15 g agar and 1,000 mL distilled water) and incubated at 37 °C for 2 days. Lipolytic activity was shown by clear zones around the colonies [13]. The Enzyme Activity Index (EAI) was determined by using the following formula: EAI = clear zone diameter/colony diameter [14]. Bacterial isolates with high EAI values were identified as strong lipase-producing bacteria and were selected for further testing.
Lipase activity of bacterial isolates
One mL of 108 CFU/mL bacterial isolates in TSB was cultured in 9 mL of the screening medium and incubated at 37 °C for 3 days. The supernatant was collected by centrifugation at 15,000xg for 10 min. Lipase activity of the supernatant was determined using the Lipase Activity Assay kit 11760 (Biosystems S.A., Costa Brava, Spain), following the manufacturer’s protocol.
Phenotypic analysis and identification of lipase-producing bacteria
Cell morphologies of lipase-producing bacteria were identified by the Gram staining procedure. The bacteria were identified by a Bruker mass spectrometry system (Bruker Company, Bruker MALDI Biotyper TOF, USA) according to the manufacturerʼs recommendations. The identification of bacterial samples at the genus and species levels was performed by comparing with the spectra in the database using Biotyper software.
PCR amplification and sequencing for lipase genes
The lipase-producing bacteria were cultured in TSB and incubated in a shaking incubator (200 rpm) at 37 °C for 24 h. The cell pellet was collected by centrifugation at 15,000xg for 15 min. Genomic DNA was extracted using cetyltrimethylammonium bromide (CTAB) [15]. The primers for PCR amplification were designed based on the coding sequences of lipase-encoding genes from A. gerneri DSM 14967. Two lipase genes of A. gerneri DSM 14967 are located at nucleotide positions 1892 - 2869 of contig 50 (lip50) and 14905 - 15903 of contig 66 (lip66). The primers used in this study are listed in Table 1. The lipase genes were amplified using PCR with i-Taq™ DNA Polymerase. The PCR conditions were initial denaturation at 94 °C for 2 min, followed by 30 cycles consisting of denaturation at 94 °C for 20 sec, annealing at 45 °C (for lip50) or 60 °C (for lip66) for 20 sec, and extension at 72 °C for 1 min. The final extension was at 72 °C for 5 min. The PCR product was purified and resolved by 0.8 %(w/v) agarose gel electrophoresis to confirm the amplicon size. The purified PCR product was sequenced using the Sanger sequencing method with primers listed in Table 1. The sequencing was performed by Macrogen (South Korea). These sequences were subsequently translated into predicted amino acid sequences by the Expasy translation tool (https://web.expasy.org/translate/).
Table 1 Primer sequences for PCR amplification and DNA sequencing.
Primer name |
Sequence (5’-3’) |
|
lip50-R |
AAACGGACTTTTCCCAA TTTTGCATTCTTCTTTA |
lip66-F lip66-R |
TTCGAATGCGCGCCT TTGCTGGGGTTGGGTGTTATTGA |
lip50_5’-lipase-R |
GCAGGGACTTTACTATCGCCT |
lip50_3’-hypothetical protein-R |
GCAATTGATCGTGACGGTGC |
lip66_5’-lipase-R |
TGTGTACGACCTGAGCTTGG |
lip66_3’-lipase-F |
GCCGGGTGATCTTGATTTTGT |
Homology analysis of nucleotide and amino acid sequences
Homology searches for both nucleotide and amino acid sequences of the lipase genes (lip55 and lip66) from lipase-producing bacteria and A. gerneri DSM 14967 were performed using BLAST software at the National Center for Biotechnology Information (NCBI) (http://www.ncbi.nlm.nih.gov/BLAST/). Similarity searches of nucleotide sequences were performed using BLASTN, which is effective for identifying closely related sequences based on nucleotide-level alignment. For protein sequences, PSI-BLAST was used to detect distant homologs through iterative, profile-based searches, while BLASTP was employed for accurate pairwise alignment of closely related proteins.
In silico prediction of properties and structures of lipase proteins
The properties and structures of lipase proteins were analyzed using online tools. The deduced number of amino acids, physicochemical properties including molecular weight, theoretical isoelectric point (pI), negatively and positively charged residues, extinction coefficient, instability index, aliphatic index, and grand average hydropathicity (GRAVY) were determined using the ProtParam ExPASy tool (https://web.expasy.org/protparam/). The prediction of conserved domains of lipase proteins was performed using CD-Search on the NCBI website (https://www.ncbi.nlm.nih.gov/Structure/cdd/wrpsb.cgi). The three-dimensional structures of the lipase proteins were predicted in silico using the intensive mode of Phyre2, available at http://www.sbg.bio.ic.ac.uk/~phyre2 [16]. The resulting models were visualized using UCSF Chimera version 1.16 [17].
Phylogenetic and multiple sequence analysis
The phylogenetic tree, based on the amino acid sequences of the lipase proteins from lipase-producing bacteria, A. gerneri DSM 14967, and other lipolytic enzymes from the NCBI database, was constructed using the Neighbor-Joining and Maximum Likelihood (ML) methods with 1,000 bootstrap replicates in MEGA X [18]. The phylogenetic tree was visualized using FigTree software version 1.4.0 (http://tree.bio.ed.ac.uk/software/figtree/). Multiple sequence alignment of amino acid sequences of lipase proteins with those of closely related lipases was performed using ClustalW.
Results and discussion
The lipase-producing bacteria isolated from grease traps in canteens at the University of Phayao revealed a total of 42 isolates that hydrolyze olive oil in the screening medium, resulting in the production of glycerol and free fatty acids [19]. These products cause a color change in bromocresol purple, leading to the formation of yellow colonies. All isolates were tested for lipolytic activity on tributyrin agar plates. The two isolates, PKY2.2 and CE4.3, exhibited large clear zones (Figure 1) and had EAI values of 2.4 ± 0.1 and 1.9 ± 0.1, respectively. The lipase activity was 8.6 U/L for PKY2.2 and 7.2 U/L for CE4.3. The higher EAI value of PKY2.2 indicates stronger extracellular enzyme diffusion, while its lipase activity supports catalytic potential, consistent with that observed in Acinetobacter junii [20], Acinetobacter haemolyticus KV1 [21], and Bacillus altitudinis Ant19 [22]. These findings suggest that PKY2.2 may represent a promising candidate for further research and potential biotechnological applications. Additionally, the phenotypic characteristics of CE4.3 and PKY2.2 revealed that they are Gram-negative coccobacilli, which were identified as A. gerneri. After CE4.3 and PKY2.2 were confirmed to be A. gerneri, information about the lipase genes of A. gerneri was searched from the GenBank database (May 2024). The search provided specific data on the A. gerneri DSM 14967 strain, which was annotated to contain two lipase genes. The first gene is located at nucleotide positions 1,892 - 2,868 of contig 50 (lip50), and the second gene is located at nucleotides 14,905 - 15,903 of contig 66 (lip66). The comparative analysis of the nucleotide sequences of these 2 genes revealed differences. This information led to the question of whether the A. gerneri CE4.3 and PKY2.2 have lipase genes similar to those of the A. gerneri DSM 14967 strain. To investigate, nucleotide sequence data from A. gerneri DSM 14967 were used to design primers for detecting and sequencing the two lipase genes. The PCR results revealed that A. gerneri CE4.3 and PKY2.2 contain both the lip50 and lip66 genes, with PCR products of approximately 900 bp and 1,000 bp corresponding to lipase genes in lip50 and lip66, respectively (Figure 2). Therefore, the results indicate that A. gerneri CE4.3 and PKY2.2 contain genes encoding lipase, enabling both strains to degrade fats.
Figure 1 Clear zone of bacterial isolates on tributyrin agar (TA). (A) PKY2.2 and (B) CE4.3.

Figure 2 PCR products of the lipase genes. M: 100 bp DNA ladder; lanes 2 and 3: lip50 from A. gerneri CE4.3 and PKY2.2; lanes 5 and 6: lip66 from A. gerneri CE4.3 and PKY2.2.
The complete sequences of the lip50 and lip66 genes from A. gerneri CE4.3 and PKY2.2 revealed that the coding sequences (CDS) were 978 bp and 999 bp in length, respectively, in both strains. These complete gene sequences were deposited in the NCBI GenBank under accession numbers PV424653-56.
A comparison of the nucleotide sequences of the lip50 and lip66 genes between A. gerneri CE4.3 and PKY2.2 was performed. The results showed a high nucleotide sequence similarity for both the lip50 and lip66 genes between A. gerneri CE4.3 and PKY2.2, with both genes also exhibiting strong similarity to their counterparts in A. gerneri DSM 14967 (Table 2). Furthermore, comparison of the amino acid sequences revealed that the Lip50 and Lip66 proteins from both strains share a high degree of similarity. The amino acid sequence similarity of Lip50 and Lip66 proteins in both strains showed a high similarity to the amino acid sequence of A. gerneri DSM 14967 (EPR83194.1) and to the alpha/beta hydrolases of A. gerneri in the NCBI database (Table 2). Therefore, the high similarity in the nucleotide and amino acid sequences of these bacterial strains suggests that A. gerneri CE4.3 and PKY2.2 share common biological processes and a similar ancestry. The amino acid sequences of Lip50 and Lip66 of A. gerneri CE4.3 and PKY2.2 showed high similarity to the alpha/beta hydrolases of A. gerneri (WP_308956982.1, WP_317117561.1) and (WP_308956046.1, WP_346803911.1, WP_312969239.1), respectively, indicating lipase proteins of A. gerneri CE4.3 and PKY2.2 were members of the alpha/beta hydrolases, which are a large group of structurally related enzymes with diverse catalytic functions [23].
Table 2 Comparison of nucleotide and amino acid sequences of lipase gene in A. gerneri CE4.3 and PKY2.2.
Gene |
Bacterial strain |
Nucleotide sequence similarity (%) |
Amino acid similarity (%) |
|||
Between bacterial isolates
|
A. gerneri DSM 14967
|
Between bacterial isolates |
A. gerneri DSM 14967 (EPR83194.1) |
Alpha/beta hydrolases of A. gerneri (Accession no.) |
||
lip50 |
A. gerneri CE4.3 |
98.47 |
98.47 |
98.77 |
98.77 |
99.38 (WP_308956982.1, WP_317117561.1) |
A. gerneri PKY2.2 |
99.49 |
99.38 |
||||
lip66 |
A. gerneri CE4.3 |
96.9 |
97.20 |
99.70 |
100 |
99.70 (WP_308956046.1, WP_346803911.1, WP_312969239.1) |
A. gerneri PKY2.2 |
97.50 |
99.70 |
||||
Predictions of physicochemical properties of Lip50 and Lip66 from A. gerneri CE4.3 and PKY2.2 were performed using the ProtParam tool. The results of the physicochemical properties are shown in Table 3. The molecular weight of all proteins ranged from 35.84 to 37.20 kDa. As reported, the lipase proteins obtained from Acinetobacter spp. have a variable molecular weight from 23 to 62 kDa [24]. The isoelectric point (pI) values of all proteins ranged from 8.72 to 8.84, suggesting that these proteins are slightly basic. The extinction coefficient (EC) values range from 0.988 to 1.072 M−1 cm−1, indicating that the proteins have a moderate absorbance of light during interaction with substrates. The aliphatic index (AI) of all proteins ranged from 96.09 to 99.25, suggesting that these proteins are thermostable. Thermostability is considered a key characteristic of lipase proteins [25]. The instability index of Lip50 in both strains was within the stability range, indicating resistance to denaturation or solubilization under different environmental conditions, while Lip66 in both strains exhibited instability. The stability of these proteins depends on the amino acid composition of their structures [26]. The grand averages of the hydropathy indices (GRAVY) of all lipases were negative, suggesting that these proteins are hydrophilic [27]. This characteristic promotes solubility and activity in aqueous environments. These lipases are particularly well-suited for applications in water-based systems, such as food processing, detergents, and bioremediation.
Table 3 Physicochemical properties of lipase proteins.
Physicochemical properties |
Lipase proteins |
|||
Lip50 |
Lip66 |
|||
A. gerneri CE4.3 |
A. gerneri PKY2.2 |
A. gerneri CE4.3 |
A. gerneri PKY2.2 |
|
1. Number of amino acids |
325 |
325 |
332 |
332 |
2. Predicted molecular weight (kDa) |
35.87 |
35.84 |
37.20 |
37.19 |
3. Theoretical isoelectric point (pI) |
8.72 |
8.73 |
8.84 |
8.84 |
4. Negatively charged residues (Asp+Glu) |
33 |
33 |
30 |
30 |
5. Positively charged residues (Arg+Lys) |
36 |
36 |
33 |
33 |
6. Extinction coefficient (M -1 cm -1) |
1.029 |
0.988 |
1.072 |
1.072 |
7. Instability index |
39.05 |
39.53 |
48.85 |
48.94 |
8. Aliphatic index |
96.40 |
96.09 |
99.25 |
98.07 |
9. Grand averages of hydropathy (GRAVY) |
−0.111 |
−0.128 |
−0.211 |
−0.227 |
The nucleotide sequences of the lip50 and lip66 genes from A. gerneri CE4.3 and PKY2.2 were translated into amino acid sequences, which were predicted to consist of 325 and 332 residues, respectively (Figure 3). Analysis of the conserved domains revealed that these lipase proteins contain MenH superfamily domain spanning amino acid positions 52 to 323 in Lip50 and 53 to 325 in Lip66 in both isolates. This domain belongs to the alpha/beta hydrolases fold family (Domain Structure ID: 11426811), which is responsible for hydrolyzing ester bonds in lipids [28]. Furthermore, the amino acid sequences of the Lip50 and Lip66 from A. gerneri CE4.3 and PKY2.2 reveal conserved regions, including the catalytic triads of Lip50 (Ser148, Asp59/119/201, and His79) and Lip66 (Ser150, Asp61/121/203, and His81) which enable the lipase enzyme to catalyze hydrolysis reactions by utilizing a nucleophile as a catalytic agent to break chemical bonds [29]. The oxyanion holes of Lip50 (His79 and Gly80) and Lip66 (His81 and Gly82) stabilize the interaction between the enzyme and the substrate [30]. The calcium-binding sites of Lip50 (Asp59/119) and Lip66 (Asp61/121) enhance protein structural stability, allowing the lipase enzyme to efficiently perform its role in lipid degradation [31].




Figure 3 The nucleotide and deduced amino acid sequences of the lip50 and lip66 genes from A. gerneri CE4.3 and PKY2.2. The start codon (ATG) and stop codon (TAA) are shown in red letters, while amino acids at the C-terminal domain (mature protein) are shown in blue letters. Bold letters indicate the expected catalytic triad. Green, yellow, and blue highlights represent the expected conserved regions (active site), while aspartate (D) residues involved in calcium binding are underlined.
The protein structures of Lip50 and Lip66 of A. gerneri CE4.3 and PKY2.2 were predicted using Phyre2. The 3D models of these lipase proteins were generated based on the crystal structure of a putative lipase (Lip1) from A. baumannii (c4opmB). The models for Lip50 of CE4.3 and PKY2.2 exhibited identity scores (percentage of amino acid sequence similarity between the query protein and the template sequence of protein used by Phyre2) of 62% and 63%, respectively. In contrast, the models for Lip66 of CE4.3 and PKY2.2 isolates showed lower identity scores of 54% and 55%, respectively. Despite these variations in identity scores, all generated models achieved a maximum confidence score (the reliability of the 3D model predicted by Phyre2) of 100%. The 3D structure displayed an alpha/beta hydrolase fold, with Ser201, His79, and Ser148 forming the catalytic active site (Figure 4).

Figure 4 3D model of lipase proteins with a zoomed-in view of the catalytic triad. (A) Lip50 of A. gerneri CE4.3, (B) Lip50 of A. gerneri PKY2.2, (C) Lip66 of A. gerneri CE4.3, and (D) Lip66 of A. gerneri PKY2.2.
The phylogenetic tree analysis showed that Lip50 from both strains are closely related to A. gerneri DSM14967 (EPR83194.1) and Lip66 from both strains are closely related to A. gerneri DSM14967 (EPR82373.1) (Figure 5). Additionally, Lip50 and Lip66 from both strains are closely related to lipase proteins from Moraxella sp. (CAA37863.1), Psychrobacter immobilis (CAA47949.1), Acetobacter pasteurianus (BAA25795.1), and Sulfolobus acidocaldarius (AAC67392.1) (Figure 5), which are members of the lipase family V [32,33]. The lipase enzyme group in family V originates from a variety of organisms adapted to different environments, such as mesophilic bacteria (Acetobacter pasteurianus), cold-adapted bacteria (Moraxella sp., Psychrobacter immobilis), and the thermoacidophilic archaeon (Sulfolobus acidocaldarius) [32,33]. Furthermore, the lipase from A. gerneri has never been previously classified into any family. Therefore, the data of Lip50 and Lip66 from both strains of A. gerneri can serve as preliminary information for the classification of A. gerneri lipases into the family V.

Figure 5 The phylogenetic tree shows the lipase proteins from contig50 and contig66 of CE4.3 and PKY2.2, represented by a red and a blue circle, respectively, together with lipase proteins from various bacterial esterase/lipase family members. The numbers at the nodes represent the bootstrap values based on 1,000 bootstrap replicates.
The multiple sequence alignment analysis of the amino acid sequences of Lip50 and Lip66 from A. gerneri CE4.3 and PKY2.2 was performed using closely related lipases. The results show that these proteins exhibit highly conserved features found in members of family V lipases (Figure 6). The catalytic triad of these lipases is composed of Ser209, Asp263/Asp335, and His140/His364, which form a conserved region. The catalytic nucleophile Ser209 is located within the conserved Gly-His-Ser-Met (Leu)-Gly-Gly motif, which corresponds to the Gly-X-Ser-X-Gly motif (where X represents any amino acid). This sequence is a characteristic feature of family V lipases [32,33]. The oxyanion hole is formed by the His-Gly motif (His140-Gly141), which stabilizes the tetrahedral intermediate during catalysis [21]. Additionally, these lipases contain aspartate residues (Asp263 and Asp335), which act as calcium-binding sites crucial for lipase activation [34]. The GH motif, which contains a histidine at the putative active site, is found in family V lipases and plays a role in hydrolysis [32]. The PTL motif is another common feature of family V, although the functions of PTLs remain less understood [35]. Based on sequence analysis, Lip50 and Lip66 from A. gerneri CE4.3 and PKY2.2 may represent novel members of the family V lipolytic enzymes. This study provides fundamental insights into the lipase-encoding genes in A. gerneri CE4.3 and PKY2.2, which can be further applied in recombinant enzyme production for various biotechnological purposes, such as the treatment of lipid-rich wastewater. Furthermore, the lipolytic capabilities of these strains should be evaluated in synthetic wastewater as a basis for treating lipid-contaminated environmental wastewater.

Figure 6 Alignment of the amino acid sequences of Lip50 and Lip66 from A. gerneri CE4.3 and PKY2.2 with other members of the lipase family V, including Acetobacter pasteurianus (BAA25795.1), Moraxella sp. (CAA37863.1), Psychrobacter immobilis (CAA47949.1), and A. gerneri (EPR82373.1, EPR83194.1), showing high sequence identity. Symbols: Asterisk (*) indicates amino acid residues of the catalytic triad; filled circle (●) represents aspartate residues involved in calcium binding sites; red highlighted boxes show conserved oxyanion holes and serine active site regions. The multiple amino acid alignments indicated that Lip50 and Lip66 from A. gerneri CE4.3 and PKY2.2 would be new members of family V.
Conclusions
Two lipase-producing bacteria were isolated from grease traps of canteens at the University of Phayao in Northern Thailand. They were identified as A. gerneri CE4.3 and PKY2.2. Both strains contain the lipase lip50 and lip66 genes. The nucleotide sequences of lipase genes in both strains closely matched that of A. gerneri DSM 14967, and their amino acid sequences showed high similarity to A. gerneri DSM 14967 (EPR83194.1). The Lip50 and Lip66 proteins from both strains were predicted to have slightly basic, thermostable, and hydrophilic characteristics. These proteins contain conserved domains characteristic of the alpha/beta hydrolase fold family and conserved regions including the catalytic triad, oxyanion hole, and calcium-binding site. Phylogenetic tree analysis showed that Lip50 and Lip66 proteins from both strains are closely related to A. gerneri DSM14967 [EPR83194.1] and [EPR82373.1], respectively. The analysis also indicates that they are closely related to lipase proteins belonging to family V. Therefore, the lipase genes of A. gerneri CE4.3 and PKY2.2 provide a foundation for further study of these lipolytic enzymes for biotechnological applications.
Acknowledgement
This research was funded by the Thailand Science Research and Innovation funds and the University of Phayao, 56000, Thailand (Grant No. FF66-RIM086).
Declaration of Generative AI in Scientific Writing
The authors acknowledge the use of generative AI tools (ChatGPT by OpenAI) in the manuscript preparation process for language editing and grammar correction. No content generation or data interpretation was performed by AI. The authors take full responsibility for the content and conclusions of this work.
CRediT author statement
Nicha Charoensri: Conceptualization, Methodology, Software, Validation, Writing-original draft and editing.
Ornampai Japa: Conceptualization, Software, Validation, and Writing-original draft and editing.
Supakanya Lasom: Conceptualization, Formal analysis, Investigation and Validation
Noppadon Muangsue: Conceptualization, Formal analysis, Investigation and Validation
Piyawan Amimanan: Conceptualization, Methodology, Investigation, Software, Validation, Funding acquisition and Writing-original draft and editing.
References
[1] B Devaraj and G Rajalakshmi. Microbial lipases: An overview of screening, production and purification. Biocatalysis and Agricultural Biotechnology 2019; 22, 101368.
[2] N Patel, D Rai, Shivam, S Shahane and U Mishra. Lipases: Sources, production, purification, and applications. Recent Patents on Biotechnology 2019; 13(1), 45-56.
[3] CA Salgado, CIAD Santos and MCD Vanetti. Microbial lipases: Propitious biocatalysts for the food industry. Food Bioscience 2022; 45, 101509.
[4] T Panyachanakul, V Kitpreechavanich, W Lorliam, T Lomthong and S Krajangsang. Optimization, purification and characterization of lipase from Streptomyces sp. A3301, with application of crude lipase for cooking oily wastewater treatment. Trends in Sciences 2024; 21(11), 8504.
[5] Y Jha. Chapter 11-Bacterial lipases: Biotechnological and industrial applications. Bacterial Secondary Metabolites Synthesis and Applications in Agroecosystem Nanobiotechnology for Plant Protection 2024; 1, 197-209.
[6] P Farrokh, B Yakhchali and AA Karkhane. Cloning and characterization of newly isolated lipase from Enterobacter sp. Bn12. Brazilian Journal of Microbiology 2014; 45(2), 677-687.
[7] VP Sutar, GV Mali, V Upadhye, VK Singh and RP Sinha. Purification of lipase from Pseudomonas aeruginosa VSJK R-9 and its application in combination with the lipolytic consortium for bioremediation of restaurant wastewater. Applied Biochemistry and Biotechnology 2023; 195, 1888-903.
[8] P Ungcharoenwiwat and AH-Kittikun. Purification and characterization of lipase from Burkholderia sp. EQ3 isolated from wastewater from a canned fish factory and its application for the synthesis of wax esters. Journal of Molecular Catalysis B: Enzymatic 2015; 115, 96-104.
[9] T Saengsanga, W Siripornadulsil and S Siripornadulsil. Molecular and enzymatic characterization of alkaline lipase from Bacillus amyloliquefaciens E1PA isolated from lipid-rich food waste. Enzyme and Microbial Technology 2016; 82, 23-33.
[10] G Sukplang, C Narasettiti, O Chunhachart, M Srithaworn, W Lorliam, S Krajangsang and T Panyachanakul. Isolation and identification of lipase-producing bacteria from wastewater treatment pond for the removal of oil and grease in wastewater treatment. Chiang Mai Journal of Science 2024; 51(6), 2024096.
[11] V Sakpuntoon, J Angchuan, W Boontham, P Khunnamwong, C Boonmak and N Srisuk. Grease waste as a reservoir of lipase-producing yeast and description of Limtongella siamensis gen. nov., sp. nov. Microorganisms 2020; 8(1), 27.
[12] K Suwansunthichai, V Kitpreechavanich, L Kraidej and L Chitradon. Rapid method for screening of high lipase producing bacteria. Agriculture and Natural Resources 1991; 25(2), 162-168.
[13] R Noormohamadi, F Tabandeh, P Shariati and M Otadi. Characterization of a lipase from a newly isolated Pseudomonas sp. Iranian Journal of Microbiology 2013; 5(4), 422-427.
[14] A Alawiaha, F Al-Sayied and O El-Hamshary. Detection and molecular characterization of lipase-producing bacteria. Egyptian Pharmaceutical Journal 2023; 22(1), 54-66.
[15] K Wilson. Preparation of genomic DNA from bacteria. Current Protocols in Molecular Biology 2001. https://doi.org/10.1002/0471142727.mb0204s56
[16] LA Kelley, S Mezulis, CM Yates, MN Wass and MJ Sternberg. The Phyre2 web portal for protein modeling, prediction and analysis. Nature Protocols 2015; 10, 845-58.
[17] EF Pettersen, TD Goddard, CC Huang, GS Couch, DM Greenblatt, EC Meng and TE Ferrin. UCSF Chimera--a visualization system for exploratory research and analysis. Journal of Computational Chemistry 2004; 25, 1605-1612.
[18] S Kumar, G Stecher, M Li, C Knyaz and K Tamura. MEGA X: Molecular evolutionary genetics analysis across computing platforms. Molecular Biology and Evolution 2018; 36(6), 1547-1549.
[19] X Zheng, X Chu, W Zhang, N Wu and Y Fan. A novel cold-adapted lipase from Acinetobacter sp. XMZ-26: Gene cloning and characterisation. Applied Microbiology and Biotechnology 2011; 90, 971-980.
[20] P Anbu, MJ Noh, DH Kim, JS Seo, BK Hur and KH Min. Screening and optimization of extracellular lipases by Acinetobacter species isolated from oil-contaminated soil in South Korea. African Journal of Biotechnology 2011; 10(20), 4147-4156.
[21] K Batumalaie, NA Mahat, MF Edbeib, FZ Huyop and RA Wahab. Characterization of a novel alkaline-stable lipase from Acinetobacter haemolyticus KV1 isolated from an oil palm mill effluent. Malaysian Journal of Microbiology 2018; 14, 640-654.
[22] VD Nimkande, S Sivanesan and A Bafana. Screening, identification, and characterization of lipase-producing halotolerant Bacillus altitudinis Ant19 from Antarctic soil. Archives of Microbiology 2023; 205, 113.
[23] N Lenfant, T Hotelier, E Velluet, Y Bourne, P Marchot and A Chatonnet. ESTHER, the database of the alpha/beta-hydrolase fold superfamily of proteins: tools to explore diversity of functions. Nucleic Acids Research 2012; 41, 423-429.
[24] G Furini, JS Berger, JJM Campos, STV Sand and JC Germani. Production of lipolytic enzymes by bacteria isolated from biological effluent treatment systems. Anais da Academia Brasileira de Ciências 2018; 90, 2955-65.
[25] J Veno, R Rahman, M Masomian, MSM Ali and NHA Kamarudin. Insight into improved thermostability of cold-adapted Staphylococcal lipase by glycine to cysteine mutation. Molecules 2019; 24(17), 3169.
[26] C Guo, R Zheng, R Cai, C Sun and S Wu. Characterization of two unique cold-active lipases derived from a novel deep-sea cold seep bacterium. Microorganisms 2021; 9(4), 802.
[27] H Wang, H Zhong, C Gao, J Zang and D Yang. The distinct properties of the consecutive disordered regions inside or outside protein domains and their functional significance. International Journal of Molecular Sciences 2021; 22(19), 10677.
[28] JT Mindrebo, CM Nartey, Y Seto, MD Burkart and JP Noel. Unveiling the functional diversity of the alpha/beta hydrolase superfamily in the plant kingdom. Current Opinion in Structural Biology 2016; 41, 233-246.
[29] AR Buller and CA Townsend. Intrinsic evolutionary constraints on protease structure, enzyme acylation, and the identity of the catalytic triad. PNAS 2013; 110(8), 653-661.
[30] A Kumari and R Gupta. Phenylalanine to leucine point mutation in oxyanion hole improved catalytic efficiency of Lip12 from Yarrowia lipolytica. Enzyme and Microbial Technology 2013; 53(6-7), 386-390.
[31] A Sahu and R Birner-Gruenberger. Encyclopedia of metalloproteins. In: RH Kretsinger, VN Uversky and EA Permyakov (Eds.). Springer, New York, 2013.
[32] JL Arpigny and KE Jaeger. Bacterial lipolytic enzymes: Classification and properties. Biochemical Journal 1999; 343(1), 177-183.
[33] SH Albayati, M Masomian, SNH Ishak, MSBM Ali, AL Thean, FBM Shariff, NDBM Noor and RNZRA Rahman. Main structural targets for engineering lipase substrate specificity. Catalysts 2020; 10(7), 747.
[34] J Yang, K Kobayashi, Y Iwasaki, H Nakano and T Yamane. In vitro analysis of roles of a disulfide bridge and a calcium binding site in activation of Pseudomonas sp. strain KWI-56 lipase. American Society for Microbiology 2000; 182(2), 295-302.
[35] H Nacke, C Will, S Herzog, B Nowka, M Engelhaupt and R Daniel. Identification of novel lipolytic genes and gene families by screening of metagenomic libraries derived from soil samples of the German biodiversity exploratories. FEMS Microbiology Ecology 2011; 78(1), 188-201.